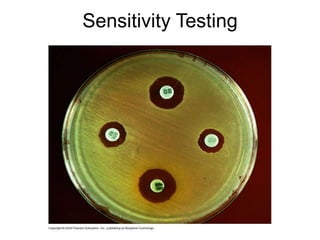
Sensitivity Testing

Alexander Fleming accidentally discovered penicillin in 1928 when he observed bacteria-free zones around mold colonies growing in petri dishes. Penicillin was the first natural antibiotic compound and works by inhibiting bacterial cell wall synthesis. Since then, over 100 different antibiotics have been discovered that work through various mechanisms like inhibiting protein synthesis or nucleic acid replication. However, antibiotic resistance has become a major problem requiring prudent antibiotic use and new antibiotic development.